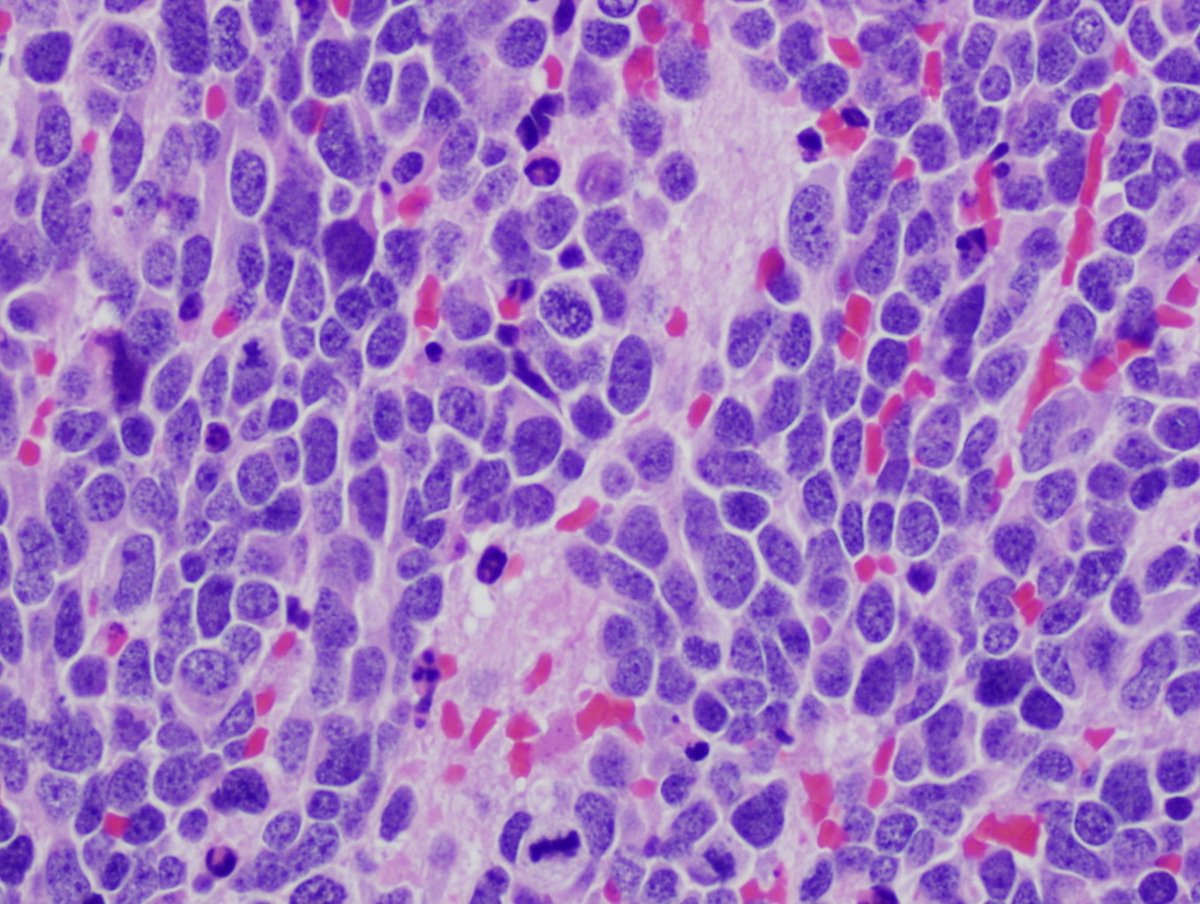
smlungpathguy's tweet image. Neuroblastoma: IHC = NB84 kikoxp.com/posts/24240
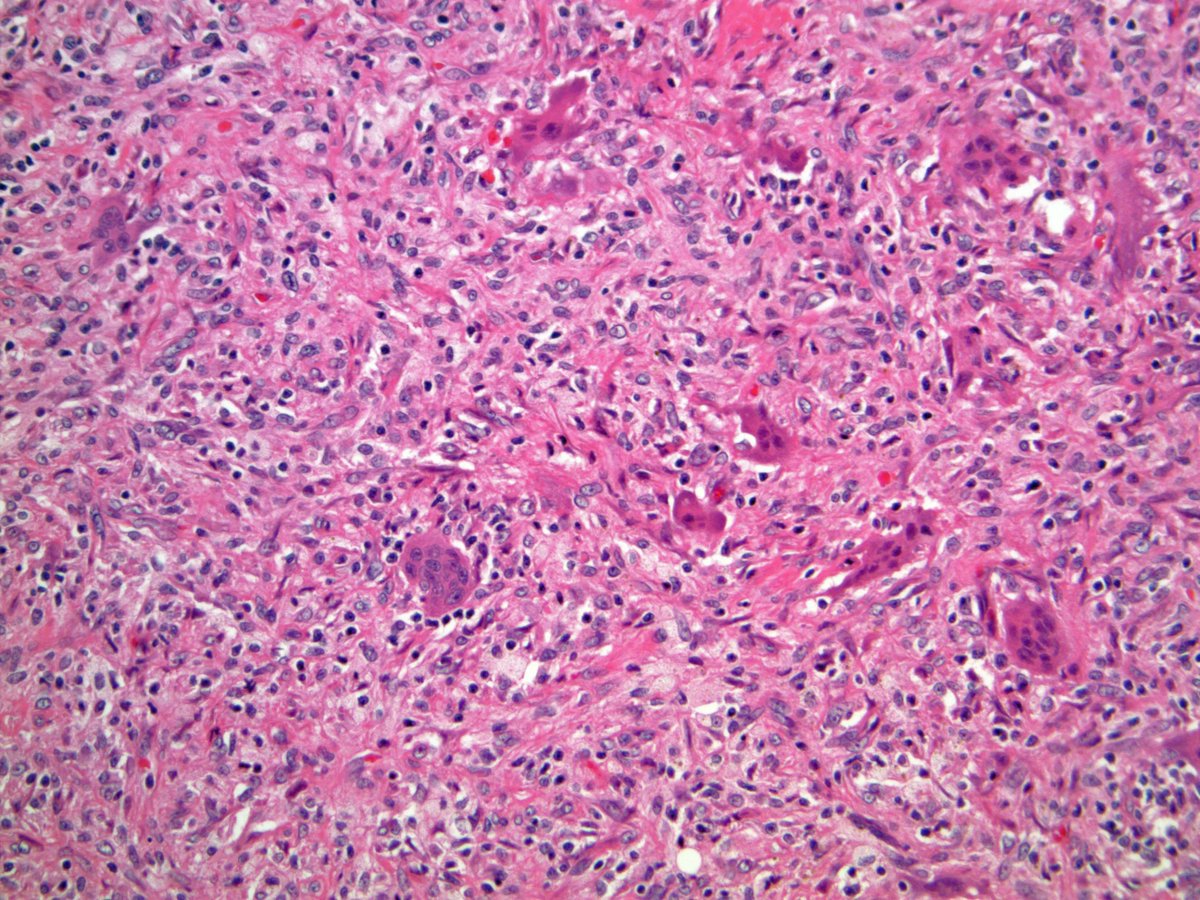
ScottBikeethan's tweet image. 20+ male with a well circumscribed subcut abdominal mass, associated with osteoclast-type giant cells, foamy histiocytes, fibrous pseudocapsule, and bland ovoid cells. Focal keratin positivity. What is your diagnosis? @CLEClinicLabs @CCFPathRes #BSTpath #pathology
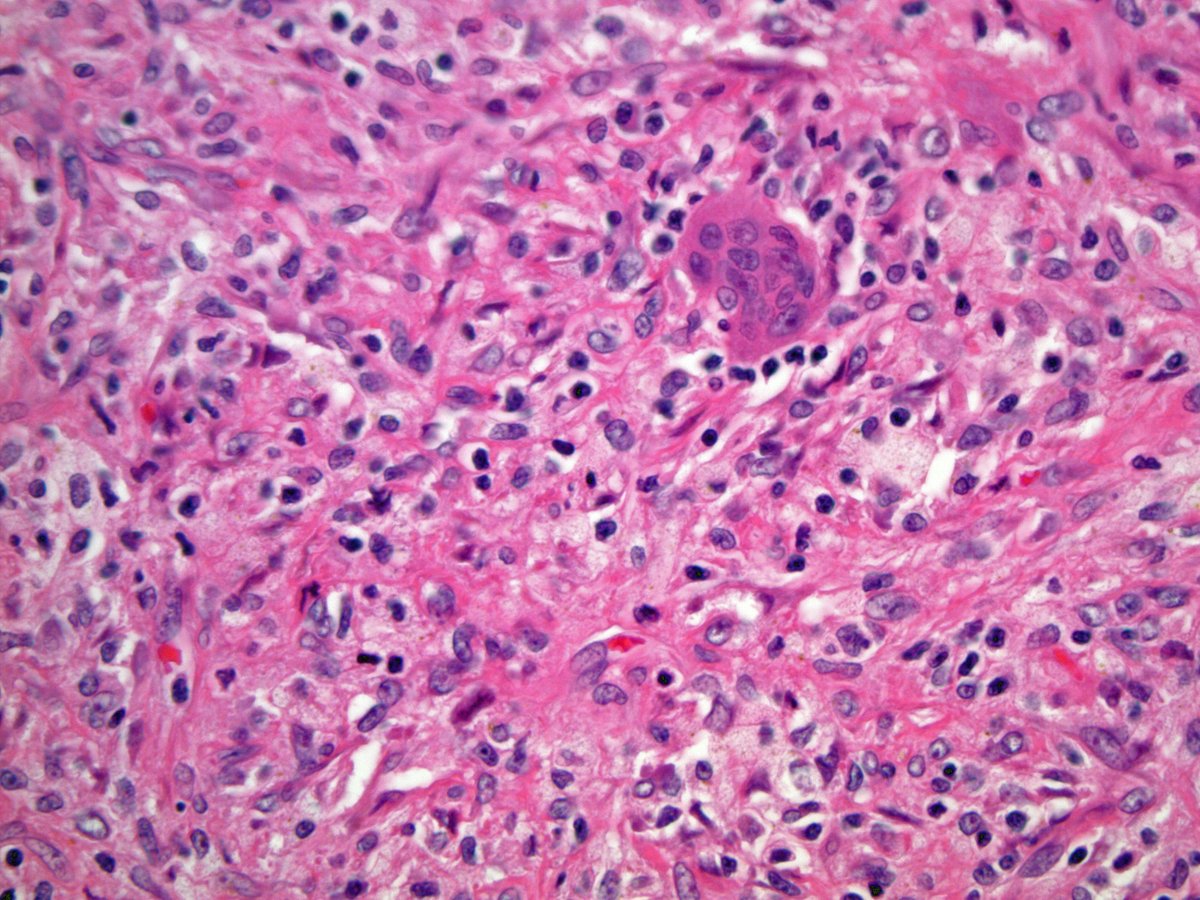
ScottBikeethan's tweet image. 20+ male with a well circumscribed subcut abdominal mass, associated with osteoclast-type giant cells, foamy histiocytes, fibrous pseudocapsule, and bland ovoid cells. Focal keratin positivity. What is your diagnosis? @CLEClinicLabs @CCFPathRes #BSTpath #pathology
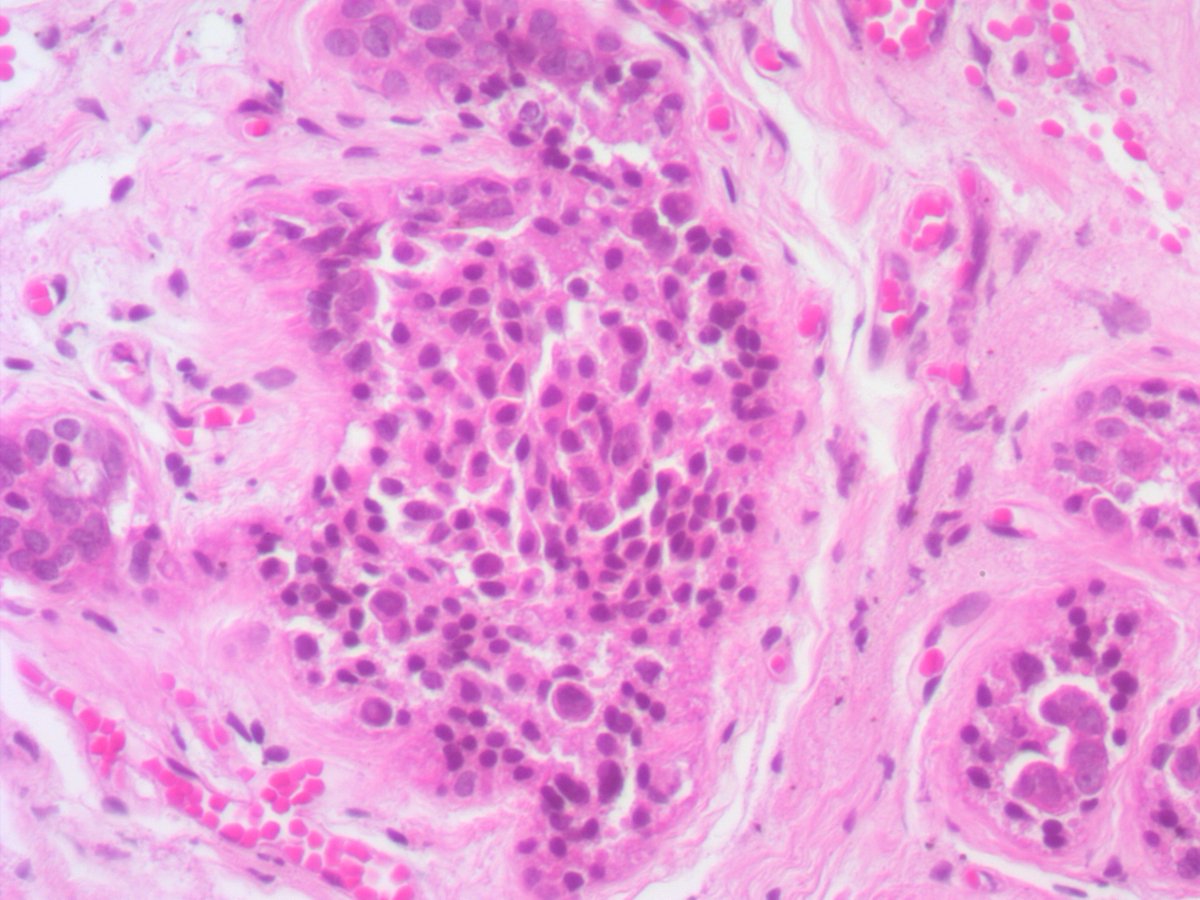
ariella8's tweet image. 1/ Dear #Breastpath your input on this axillary accessory breast, late 20's 
some findings  seem artifactual discohesiveness but some big nuclei is of concern
a lot of different columnar cell changes/blunt duct adenosis too, see next posts 😊🙏

The Pathologist Online Community
@ThePathologist2
The Pathologist Online Community Sharing knowledge, experience and best practices #PathTwitter #Path2Path
You might like
Happy Medical Laboratory Professionals Week! ASCP thanks you for the work you do every day to improve patient care! We hope you have a great week celebrating! Watch our channels for ways to celebrate all week long. #ASCPLABWEEK2023

Cyst from the thigh of a child. Your diagnosis? Answer here: kikoxp.com/posts/6923. #pathology #pathologists #pathTwitter #dermpath #dermatology #dermatologia #dermtwitter



What medication is responsible for these bone marrow findings? #hemepath #pathology



This one for upcoming and aspiring pathology residents! "Cribriform" = pierced by many small holes or a sieve-like architecture. Here, an image of cribriform prostatic carcinoma. What are other examples of cribriform architecture in pathology? (comment below) #PathtoPath #PathArt

Neuroblastoma: IHC = NB84 kikoxp.com/posts/24240
Thyroglossal duct cyst in all its undulating ciliated beauty. Too perfect not to share #beautyinthebenign

Metanephric adenoma 🔵 Cellular blue tumor composed of tightly packed tubules 🔵 Sharp interface between tumor and surrounding renal parenchyma 🔵 PAX8/WT1/CD57/BRAF (+) 🔵 Diffdx: Papillary RCC, solid variant and epithelial predominant Wilms tumor #kidneytumor #beautyinbenign




Histology flash card Testis: Germ cell tumours (GCT) 95% all testicular tumours Peak age 30 yrs (range 20-50) Oft slow growing painless mass 1-2% bilateral (oft classical seminoma) Histo 60% Mixed GCT Prognosis ➡️ morphology dependent p53 mut common #PathTwitter




#oneimagediagnosis #NotSoBoringAppendix Endometriosis of the appendix @varunksingh


Case of the year! How many well differentiated #NET of #gallbladder have you seen? It is extremely rare. And how many of them also had an #adenocarcinoma? My first case in 22 years! #Pathology never fails to highlight my day...

20+ male with a well circumscribed subcut abdominal mass, associated with osteoclast-type giant cells, foamy histiocytes, fibrous pseudocapsule, and bland ovoid cells. Focal keratin positivity. What is your diagnosis? @CLEClinicLabs @CCFPathRes #BSTpath #pathology

"Cyst" on the trunk of an adult. Your diagnosis? (Hint: it's not a cyst!) Answer: kikoxp.com/posts/8892 Video: kikoxp.com/posts/4093 #pathology #pathologists #pathTwitter #dermpath #dermatology #dermatologia #dermtwitter #BSTpath




This patient received a kidney transplant 10 days prior and is currently anuric, with delayed graft function. What is your diagnosis? #Nephtwitter #kidneypath

1/ Dear #Breastpath your input on this axillary accessory breast, late 20's some findings seem artifactual discohesiveness but some big nuclei is of concern a lot of different columnar cell changes/blunt duct adenosis too, see next posts 😊🙏

A very difficult case. One picture, what is going on? #Pathology

As reported at this year's USCAP meeting, Brunner glands in the duodenum can undergo papillary and IPMN-like changes. This section doesn't do a great job showing off the papillary architecture, but man, it looks neat! #pathology #gipath


Breast - core biopsy series 💉 Intraductal papilloma #breastpath #everydaybreast #pathology #PathResident #pathfellow #beautyinthebenign #PathTwitter


CC263. Gloomy Sunday case. Intraoperative from neurosurgery. In his 60s. CT: glioblastoma or metastasis. No relevant history. -Pepe would you take a look? -Of course @premcharles @LoboAnandi @dr_amenona @DrBMcGinn @vincepolizzi @edusqo @vi_monappa @sarahjwu


60/M FNAC-Thyroid #cytopath #pathtwitter #thyroid @pepeheffernan @vi_monappa @DrLakshmirao2 @mathuraiims @nucleololailo @kr_abhisek




United States Trends
- 1. Tomodachi Life N/A
- 2. Hugh Morris N/A
- 3. Fulton County N/A
- 4. Emmanuel Acho N/A
- 5. Georgia N/A
- 6. Taliban N/A
- 7. $MSFT N/A
- 8. Lowe N/A
- 9. Good Thursday N/A
- 10. Miis N/A
- 11. #ThursdayThoughts N/A
- 12. Hobi N/A
- 13. Sonya Massey N/A
- 14. Tom Homan N/A
- 15. #thursdayvibes N/A
- 16. Nintendo N/A
- 17. Happy Friday Eve N/A
- 18. #BridgertonSeason4 N/A
- 19. Amy Klobuchar N/A
- 20. Hagler N/A
Something went wrong.
Something went wrong.























































































































































